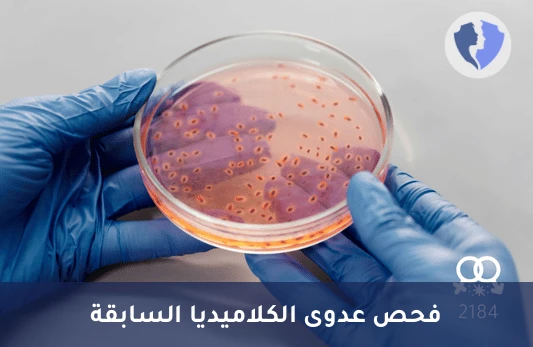
فحص أجسام كلاميديا IgG - تحليل أجسام مضادة للكلاميديا (Chlamydia IgG)

تفاصيل الخدمة
فحص أجسام كلاميديا IgG - تحليل أجسام مضادة للكلاميديا (Chlamydia IgG)
قياس الأجسام المضادة IgG للمطثمة الحثرية في مصل الدم فحص مناعي للكشف عن عدوى الكلاميديا الحالية أو السابقة أداة تشخيصية مهمة لتقييم العدوى المنقولة جنسياً